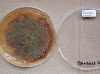

日時: 2012年6月21日(木)~6月23日(土)
場所: 筑波大学菅平高原実験センター(長野県)
講師: 矢口 貴志 先生 (千葉大学真菌医学研究センター)
本年度の菌学ワークショップは、平成24年6月21日から23日に、筑波大学菅平高原実験センターにおいて、千葉大学真菌医学研究センターの矢口貴志先生を講師にお迎えし開催されました。参加者は23人で、募集人数よりも若干少なかったですが、昨年と同様に若手の参加者が多く、活気のあるワークショップとなりました。今回のワークショップは、Aspergillus属とそのテレオモルフに関する形態分類の体得と近年の分類学的動向の理解に力点がおかれたものでした。
初日は、Aspergillus属とそのテレオモルフの形態や分類に関する基礎的な講義により入門者の理解を助けて頂きました。続いて、分子系統解析や交配型遺伝子などを用いた最近の分類学的な動向に関する話題の講義をして頂きました。2日目は、実体顕微鏡と透過型顕微鏡を用い、事前に用意されたAspergillus 属とその関連テレオモルフの主要な27種の形態観察を行いました。3日目は、引き続き27種の形態観察を行いました。
1日半程という限られた時間の中で27種もの形態観察を行うのは非常に体力を必要としますが、Aspergillus属の美しさに魅了された参加者の多くは殆どの種を観察することができたようです。終始実験室が熱気に包まれていたのはいうまでもありません。参加者の中にはこれまでAspergillus属の形態観察を行ったことのない方からそうでない方までいらっしゃいましたが、矢口先生の分かり易い説明と各々のレベルに合わした的確なコメントのお蔭で多くの方が興味を深めることができたのではないかと思います。
詳細は未定ですが、来年は研究手法に関するワークショップを企画したいと考えております。多くの方々の参加を期待しております。
企画幹事 広瀬 大